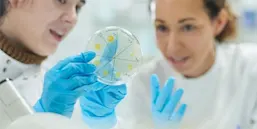
Step forward: PATHPrimer - Dr. Antonio Hugo Campos, Rede D’or Hospital (Brazil)

Today as never before you are looking to find the best way to help support your patients — hear from users about how they’re using our products
Our clinical decision support solutions — ClinicalKey, STATdx, ExpertPath, ImmunoQuery, RADPrimer and PathPrimer — help you find the right answers in the way that is needed in these challenging times. Hear stories from our users from around the globe about how they adapted their practices with Elsevier’s evidence-based decision support solutions.
Hear what your colleagues from around the world have to say
ClinicalKey AI testimonials - Strengthen your confidence with trusted content and AI
ClinicalKey testimonials — trusted content to support physicians, nurses, pharmacists and medical students
Get Involved – Share your experience with Clinical Decision Support solutions
By sharing how you’ve adapted your practices by using Elsevier’s Clinical Decision Support solutions in your workflow, you will be part of Step forward - a group of healthcare professionals sharing the best way to help support patients.
STATdx testimonials — a comprehensive radiology solution
ExpertPath & ImmunoQuery testimonials — bringing the expertise together
More testimonials for Immunoquery and ExpertPATH
RADPrimer testimonials — a comprehensive online radiology curriculum
PATHPrimer testimonials — a comprehensive online learning environment for pathology
Clinical Skills — Clinical skills for competency management and nursing procedures
Learn more about Elsevier clinical reference solutions to support your care teams